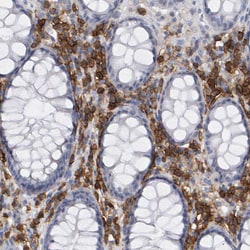
Invitrogen CD38 Polyclonal Antibody 100 &mu;L | Buy Online | Invitrogen&trade; | Fisher Scientific

missing translation for 'onlineSavingsMsg'
Learn More
Learn More
Invitrogen™ CD38 Polyclonal Antibody


Description
Immunogen sequence: AACDVVHVML NGSRSKIFDK NSTFGSVEVH NLQPEKVQTL EAWVIHGGRE DSRDLCQDPT IKELESIISK RNIQFSCKNI YRPDKFLQCV KNPEDSSCTS EI Highest antigen sequence indentity to the following orthologs: Rat - 57%, Mouse - 53%.
CD38 is a multifunctional ectoenzyme and type II transmembrane glycoprotein involved in various cellular processes. It catalyzes the conversion of NAD into secondary messengers such as nicotinic acid adenine dinucleotide phosphate (NAADP) and cyclic ADP-ribose (cADPR). CD38 plays a crucial role in B cell development, with expression levels fluctuating from high in immature cells to low in intermediate ones, and back to high in mature B cells. It is also present in a variety of tissues and hematopoietic cells, including T cells, NK cells, and monocytes, and is used to phenotype leukemias and monitor HIV-1 progression. The CD34+CD38- population is considered to define the most pluripotent hematopoietic stem cells. In addition to its surface expression, CD38 has been identified in the nucleus, where it may regulate calcium levels. It functions as a multi-catalytic ectoenzyme, serving roles as an ADP-ribosyl cyclase, cyclic ADP-ribose hydrolase, and possibly NAD+ glycohydrolase, or as a cell surface receptor. CD38 is involved in the activation, proliferation, and differentiation of mature lymphocytes and mediates apoptosis of myeloid and lymphoid progenitor cells. It also participates in cell adhesion, signal transduction, and calcium signaling. Antibodies to CD38 are valuable for subtyping lymphomas and leukemias, detecting plasma cells (such as in myelomas), and marking activated B and T cells. CD38 is expressed at high levels in the pancreas, liver, kidney, malignant lymphoma, and neuroblastoma. Dysfunctions in CD38 are associated with diseases like chronic lymphocytic leukemia and Richter's Syndrome.

Specifications
Specifications
| Antigen | CD38 |
| Applications | Immunohistochemistry (Paraffin), Western Blot, Immunocytochemistry |
| Classification | Polyclonal |
| Concentration | 0.3 mg/mL |
| Conjugate | Unconjugated |
| Formulation | PBS with 40% glycerol and 0.02% sodium azide; pH 7.2 |
| Gene | CD38 |
| Gene Accession No. | P28907 |
| Gene Alias | 2'-phospho-ADP-ribosyl cyclase; 2'-phospho-ADP-ribosyl cyclase/2'-phospho-cyclic-ADP-ribose transferase; 2'-phospho-cyclic-ADP-ribose transferase; ADPRC 1; ADPRC1; ADP-ribosyl cyclase 1; ADP-ribosyl cyclase/cyclic ADP-ribose hydrolase 1; cADPr hydrolase 1; Cd38; CD38 antigen; CD38 antigen (ADP-ribosyl cyclase / cyclic ADP-ribose hydrolase); CD38 antigen (p45); CD38 antigen p45; CD38 molecule; CD38H; Cd38-rs1; cluster of differentiation 38; cyclic ADP-ribose hydrolase 1; ecto-nicotinamide adenine dinucleotide glycohydrolase; I-19; NAD(+) nucleosidase; NAD+ nucleosidase; NIM-R5 antigen; T10 |
| Gene Symbols | CD38 |
| Show More |
Product Title
By clicking Submit, you acknowledge that you may be contacted by Fisher Scientific in regards to the feedback you have provided in this form. We will not share your information for any other purposes. All contact information provided shall also be maintained in accordance with our Privacy Policy.
Spot an opportunity for improvement?